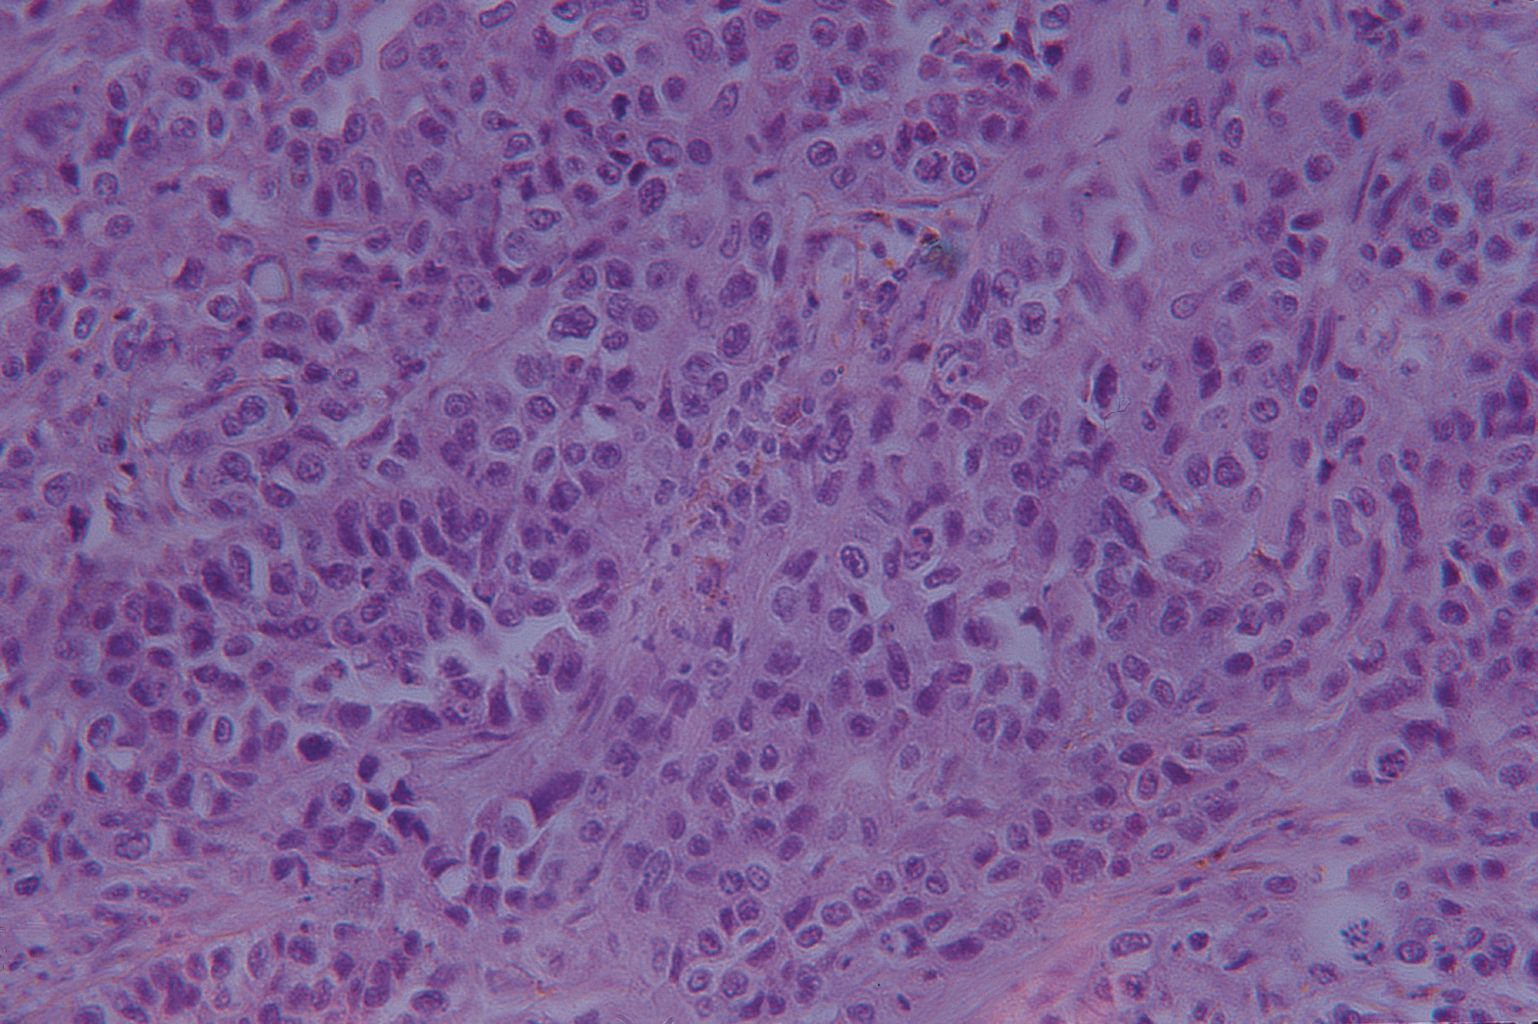

Lung Carcinoma (Sect) H&E Slide (Human) ,Each
$ 8.72
|
|
Details:
LUNG CARCINOMA (SECT) H/E SLIDE (HUMAN)
Additional Information
| SKU | 23379552 |
|---|---|
| UOM | EACH |
| UNSPSC | 41123202 |
| Manufacturer Part Number | WARD470183-262 |
| Product Dimensions | 3X0.05X1 Inches |
| Product Weight | 0.05 |
